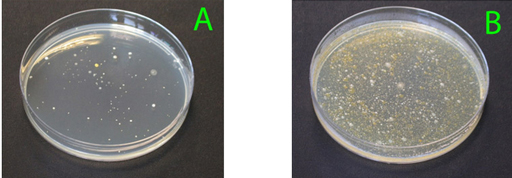

9.4.1 Microbial parameters
Drinking water can be contaminated with human or animal faeces, which are a source of pathogenic bacteria, viruses, protozoa and helminths. Measurement of microbial parameters involves the microbiological tests for faecal contamination that you read about in Study Session 2.
What are the tests widely used to assess faecal contamination?
The usual tests are for total coliform bacteria, faecal coliform bacteria and E. coli.
Table 9.1 shows the Ethiopian bacteriological standards for drinking water. It includes total coliforms and E. coli, and also mentions total visible colonies of organisms (Figure 9.6) and faecal streptococci. These are additional ways of measuring the microbial contamination of water. For all four parameters shown here the standards state that none should be present in drinking water.
| Substance | Maximum permissible level |
| Total visible organisms, colonies per 1 ml | Must not be detectable |
| Faecal streptococci per 100 ml | Must not be detectable |
| E. coli, number per 100 ml | Must not be detectable |
| Total coliform organisms, number per 100 ml | Must not be detectable |
To conduct a visible colony test, a known volume of water is spread on a nutrient layer in a Petri dish. After incubation, colonies of bacteria grow and can be counted. If there are too many colonies to count (as in B) then a diluted sample of the same water should be used (A).
9.4 Water quality standards
